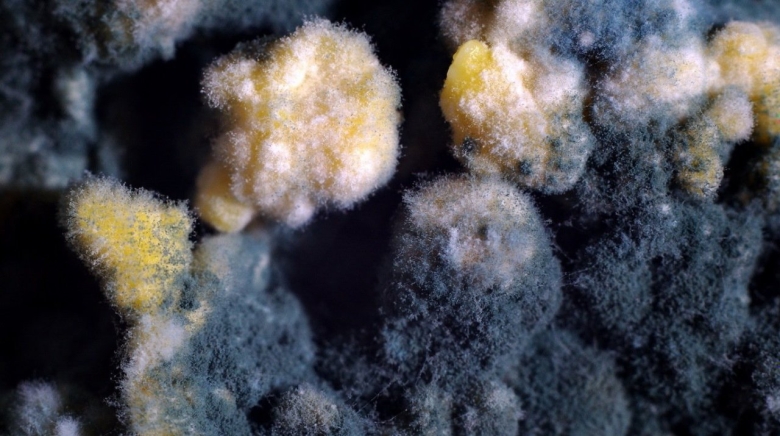
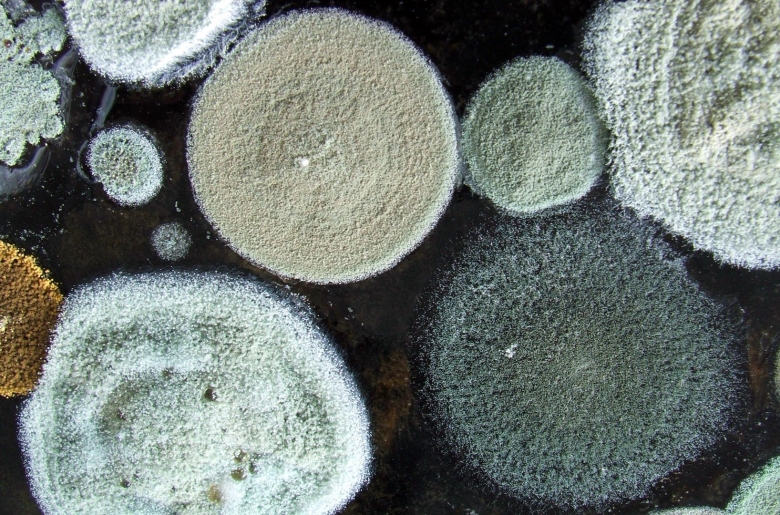
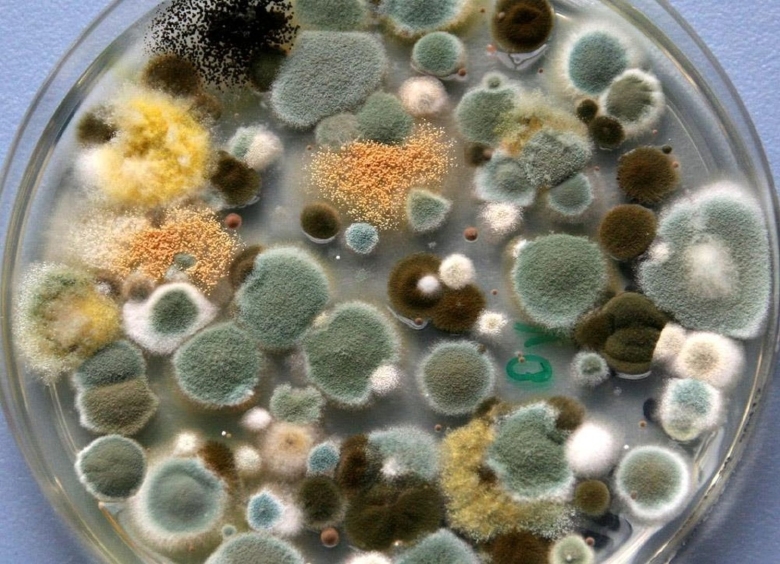
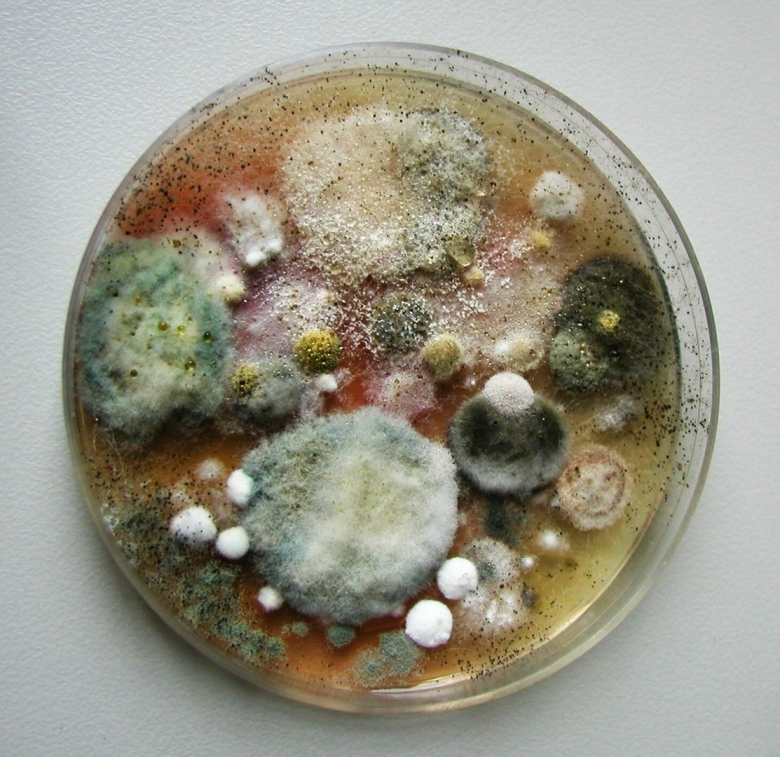
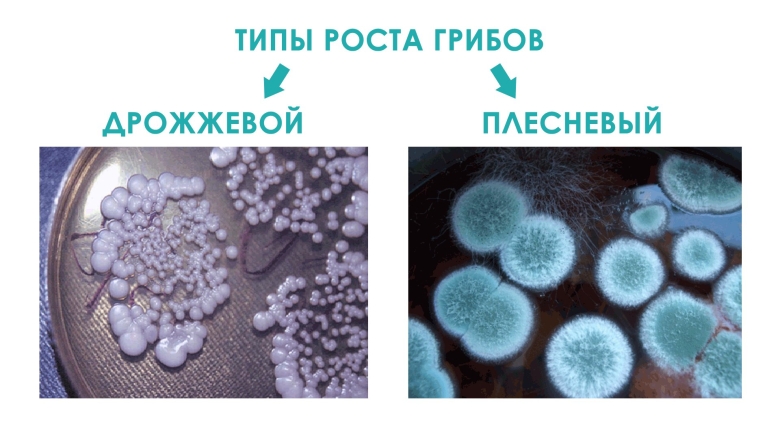
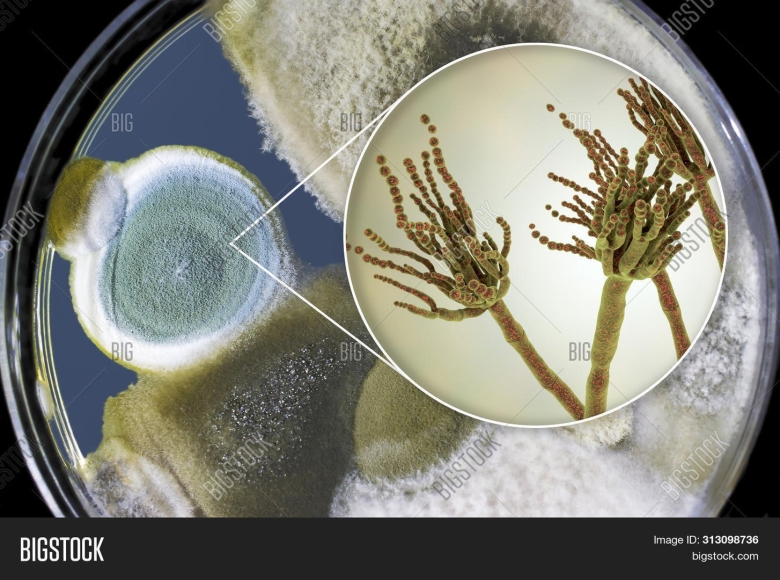
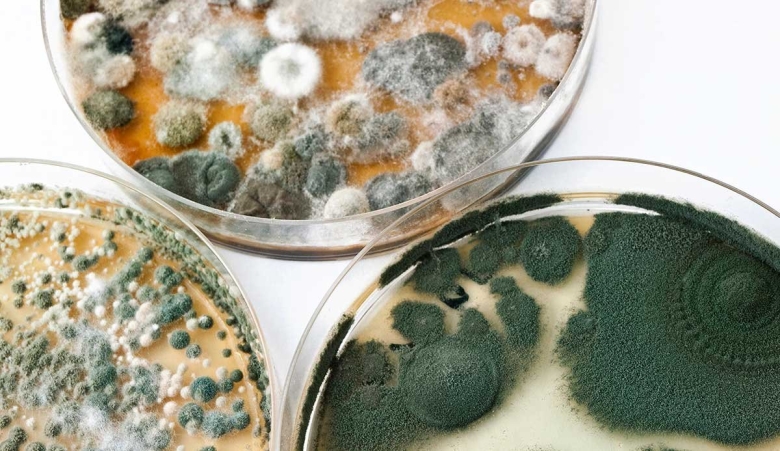
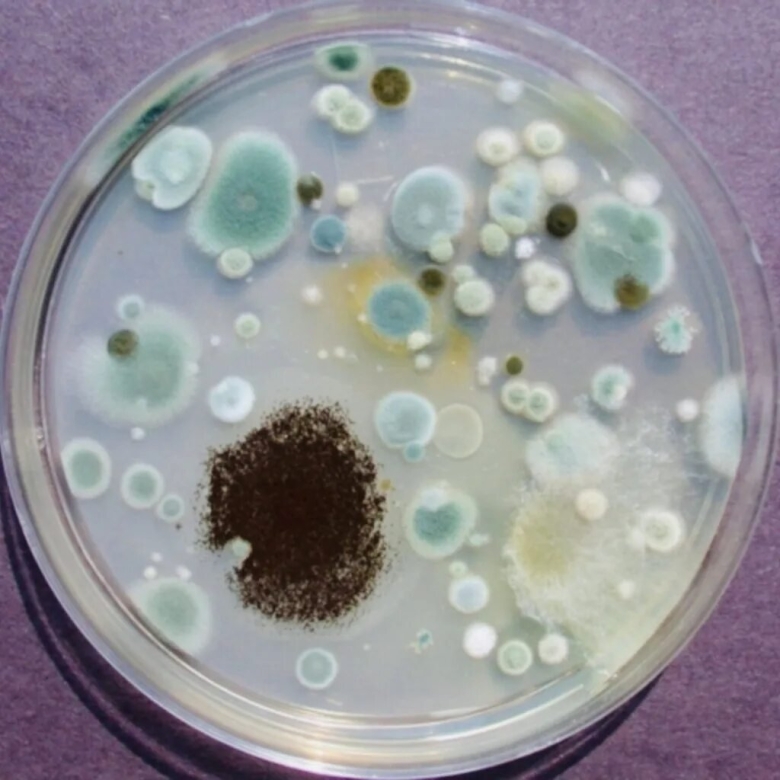

Виды плесневых грибов (59 фото)

Презентация на тему плесневые грибы

Плесневые грибы Rhizopus

Плесневые и дрожжевые грибы

Плесневые грибы на хлебе

Зеленая плесень Trichoderma
Плесень bipolaris

Плесень bipolaris

Микроскопические плесневые грибы
Плесени Aspergillus oryzae

Плесневые грибы ризопус

Строение плесневого гриба пеницилла
Плесневые грибы аспергилл

Мицелиальные микроскопические грибы

Гриб пеницилл на хлебе

Жизненный цикл гриба пеницилла

Гриб Physarum polycephalum
Плесневые грибки

Зеленая плесень пеницилл на хлебе

Грибница плесени

Мицелиальные микроскопические грибы

Гриб пеницилл на хлебе
Плесневелые грибы микробиология

Строение плесневого гриба пеницилла

Мукор пеницилл аспергилл

Мицелиальные плесневые грибы

Черная плесень аспергилл черный

Цикл развития гриба мукора

Плесневые дрожжи

Плесневые грибы Mucor

Плесневые грибы микробиология строение

Плесень пеницилл на хлебе

Ризопус мицелий

Благоприятные условия для плесени

Гриб пеницилл на хлебе

Плесневелые грибы мукор и пеницилл

Строение плесневого гриба пеницилла

Плесневые грибы Rhizopus

Mucor источники инфекции

Виды грибов Шляпочные плесневые дрожжи

Зеленая плесень Trichoderma

Хлебная плесень ризопус

Плесневые грибы аспергилл

Плесневый гриб пеницилл

Гриба мукора под микроскопом

Aspergillus на Сабуро

Материалы для исследования в микробиологии

Плесневые грибы аспергиллус

Мукормикоз черная плесень

Аменсализм гриб пеницилл

Плесневый гриб мукор на хлебе

Плесневые грибы аспергилл

Плесень пеницилл

Черная плесень аспергиллус

Актиномицеты конидии
Плесневый гриб аспергилл

Плесневые грибы

Зигомицеты мицелий

Чашка Петри микробиология

Гриб пеницилл на хлебе

Плесени aspergillus oryzae

Грибы мукор пеницилл дрожжи

Грибы сапрофиты мукор

Белая плесень мукор

Строение гриба мукора

Полезная плесень

Зеленая плесень

Строение мицелия мукора

Мицелиальные микроскопические грибы

Строение белого плесеня мукора
Микотоксины плесени

Пеницилл и аспергилл

Плесень мукор под микроскопом

Грибы рода аспергиллус

Конидии аспергилла

Хлебная плесень мукор

Зеленая плесень пеницилл на хлебе

Плесень Макросъемка

Чашка Петри с питательной средой
Плесень в чашке Петри

Грибы рода аспергиллус

Грибковая плесень

Мукор пеницилл аспергилл

Черная плесень мукор

Строение плесневых грибов пеницилл

Гриб пеницилл строение

Дрожжи плесневые шляпочные паразитические грибы

Spinellus fusiger

Чашка Петри с плесенью пенициллиум

Плесень грибок

Плесневелые грибы

Плесень пеницилл на хлебе

Penicillium roqueforti

Плесневые грибки под микроскопом

Волосатик плесень

Чашка Петри с плесенью пенициллиум
Поделиться фото в социальных сетях:
Комментариев (0)
Похожие фото:











